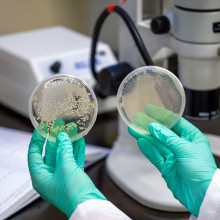
fruit fly petri dishes

The Buzz Around Kidney Stone Research
Tucked in the back of the Microbiome and Probiotic Research Lab at St. Joseph’s hospital sits the Fly Room – a small space that houses even smaller insects whose microscopic innards could hold clues into the link between antibiotic use and the formation of kidney stones.
Kidney stones are a growing problem, especially among women and young children.
Researchers at Lawson Research Institute (Lawson) of St. Joseph’s Health Care London have turned to an unlikely source – the humble fruit fly as helper, not house pest - to see whether oral antibiotic use is partly to blame. Previous research has shown that people with kidney stones have an imbalance in the gut microbiome and a genetic footprint that could suggest resistance to antibiotics.
The question Lawson researcher Riley Fidler is trying to solve: Is antibiotic use shifting microbiome balance and making otherwise-healthy individuals more susceptible to kidney stones?
At the centre of her research is an unlikely research ally. No bigger than a sesame seed, fruit flies share about 70% of their genes with humans - making the insects ideal stand-ins for genetic research into human diseases. This similarity is especially relevant in fruit flies’ Malpighian tubules, or excretory organs, and in human nephrons, the functional unit of the kidneys.
"By maintaining good gut health, in turn, your gut microbiota will keep you healthier."
If a fruit fly is the size of a sesame seed, their tubules are smaller than the hairs on a raspberry. And “kidney stones” within their tubules are even tinier.
It is exacting and exciting research, says Fidler, a Master of Science Student in Western University’s Department of Microbiology and Immunology and a researcher alongside Principal Investigator, Jeremy Burton, PhD, Chair in Human Microbiome and Probiotics and Co-Supervisor Dr. Kait F Al, PhD, post-doc researcher.
Fidler is fascinated by the human microbiome and its impact on health – from metabolism and stress to mental health, the ability to fight infection, and even to prevent and overcome cancer. "By maintaining good gut health, in turn, your gut microbiota will keep you healthier."
If the team can identify whether antibiotic use could be an underlying cause of kidney stones, prevention strategies that strengthen gut health could be used in tandem with an antibiotic to repair gut barrier integrity.
“Kidney stone disease has a high prevalence, high rate of recurrence and high pain. Finding the cause of the increased cases of kidney disease and knowing how to prevent stone-formation is critical for quality of life,” says Fidler.
Fidler’s research looks at four antibiotics commonly prescribed to fight infections (both related and unrelated to kidney function) in people: cefazolin, ciprofloxacin, penicillin and sulfamethoxazole-trimethoprim.
Fidler places different fruit fly populations into containers with different antibiotics. Then she removes the insects’ two pairs of tubules and examines them with birefringence microscopy, a technique that uses light and special filters to see things otherwise invisible to the naked eye, to see the microscopic kidney stones that grew within the tubules after the flies were supplemented with antibiotics. Computer software then quantifies the stone load.
The hope is, once researchers understand the correlation between antibiotics and the formation of kidney stones, this could promote antibiotic stewardship – fewer unnecessary antibiotic prescriptions – and lead to more targeted treatment strategies. For children specifically, this research could help practitioners know which antibiotic is best for children to avoid kidney stones.
For Fidler, doing this research in a hospital-based research institute is critical. As she seeks guidance from urologists at St. Joseph’s and others affiliated with Western University, Burton works closely with other researchers and clinicians at St. Joseph’s in infectious diseases, urology and surgery to understand issues facing patients in clinical practice.
This knowledge directly improves the work being done in the Microbiome and Probiotic Lab, and other labs across Lawson.
Recently, Fidler presented this research at the 2025 American Urological Association Annual Meeting in Las Vegas, Nevada, where she won best poster presentation in her session.
“I love research because I use each result to determine what experiments I should perform next. And in the end, I am able to communicate a story using all my results that can be tied together,” says Fidler. “To produce good work and overcome the many challenges in research, you must be very passionate about what you do.”
“A lot of people view bacteria as dangerous agents, but I would suggest that we view the microbiome almost as our ‘sidekick’,” says Fidler.